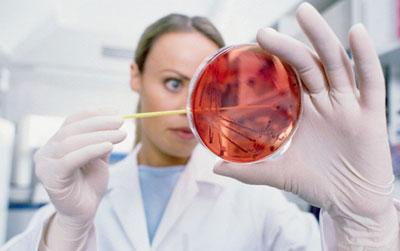
Анализ рпга

Брюшной тиф – это острое инфекционное заболевание, которое вызывается брюшнотифозной палочкой. Путь передачи – алиментарный, механизм – фекально-оральный. Возбудитель вызывает бактериемию (большое количество брюшнотифозной палочки в крови), высокую интоксикацию, поражает лимфатический аппарат тонкого кишечника, печень и селезенку (органы увеличены в размерах). Диагностический анализ на брюшной тиф первые дни болезни затруднен. Это связано с тем, что инфекционный процесс может протекать в атипичной или скрытой форме. Поэтому при любом виде лихорадки, независимо от ее интенсивности, диагностику на брюшной тиф делают 5 дней подряд.
Характеристика и особенности возбудителя брюшного тифа
Инфекцию вызывает возбудитель из рода сальмонелл – Salmonella typhi. Это подвижная грамотрицательная палочка, которая живет в условиях доступа кислорода. Она не способна образовывать споры, но очень устойчива в условиях внешней среды. Находясь в воде, тифозная палочка сохраняет жизнеспособность от 1 до 5 месяцев. В испражнениях она активна на протяжении 25 дней.
При умеренном охлаждении, например, в холодильнике, микроорганизм в молочных продуктах не только сохраняется, но и способен к размножению в течение месяца. Высокие температуры губительно воздействуют на возбудителя. При кипячении тифозная палочка погибает моментально. Если нагреть воду до 60°C, то микроорганизм погибнет через 4-5 минут. Под действием прямых солнечных лучей он также теряет жизнеспособность.
Тифозная палочка очень чувствительна к химическим дезинфицирующим веществам. При воздействии хлорамина, сулемы, лизола она обеззараживается за несколько минут.
Тифозная палочка имеет сложную антигенную структуру. Но для диагностических целей используют только два антигенных комплекса: О-антиген (термостабильный соматический) и Vi-антиген (термолабильный жгутиковый). Патогенный микроорганизм способен образовывать L-формы, которые способствуют развитию бактериального носительства и рецидивов брюшного тифа.
Врачи подчеркивают важность комплексного подхода к диагностике брюшного тифа, который включает в себя несколько видов анализов. Первостепенное значение имеет бактериологический анализ, при котором из образцов крови, кала или мочи выделяют возбудителя инфекции — Salmonella typhi. Этот метод позволяет не только подтвердить диагноз, но и оценить чувствительность бактерий к антибиотикам.
Кроме того, врачи рекомендуют проводить серологические исследования, такие как тест на наличие специфических антител, что может помочь в ранней диагностике, особенно в случаях, когда бактериологический анализ дает отрицательный результат. Также важно учитывать клинические проявления заболевания и проводить общие анализы крови и мочи для оценки состояния пациента.
Таким образом, сочетание различных методов диагностики позволяет врачам более точно установить диагноз и назначить эффективное лечение, что особенно критично для предотвращения осложнений.
https://youtube.com/watch?v=tzOAxWEXIT4
Дифференциальная диагностика заболевания
По клинической картине брюшной тиф схож с другими инфекционными заболеваниями. Поэтому
важно отличить его по проявляющимся симптомам от таких болезней, как сыпной тиф, бруцеллез, грипп, менингококковая инфекция, лихорадка КУ (коксиеллез)
.
Отличительные признаки брюшного тифа:
- острое начало болезни только в 1/3 случаев;
- нарушение сна, слабость и головная боль нарастают постепенно;
- кожа становится бледной и сухой;
- заторможенность реакций;
- интоксикация организма прогрессирует постепенно;
- температура тела поднимается медленно, но переносится больными тяжело, при этом пациенты не потеют, кожа остается сухой;
- сердцебиение замедляется, незначительно снижается артериальное давление, при аускультации тоны сердца приглушены;
- появляется мягкий влажный кашель, который переходит в ранний бронхит;
- живот вздут, слышны урчания, которые локализуются в правом подреберье (область печени).
Раннее выявление тифозной палочки
Для выявления брюшного тифа на ранних этапах болезни используют посев крови – анализ на гемокультуру. Это обусловлено тем, что инфекционная болезнь сопровождается интенсивной бактериемией именно первые дни заболевания, в поздний период болезни количество тифозной палочки в крови становится значительно меньше.
Для выделения возбудителя взятую у пациента кровь засеивают на специальную питательную среду – мясопептонный бульон.
Для исследования сдают венозную кровь из локтевой вены в количестве 10-15 мл все пациенты с высокой температурой. В некоторых случаях при подозрении на брюшной тиф посев крови могут проводить при нормальной температуре у больного. Кровь засевается сразу же после взятия и отправляется в лабораторию.
Сколько делается анализ? Предварительные данные можно получить через двое суток. Окончательный результат известен на 4-5 сутки. Чтобы подтвердить диагноз, исследование на гемокультуру проводят 2-3 раза.
Чтобы повысить качество посева и роста микроорганизма, за 20 минут до забора крови пациенту вводят адреналин. Посев крови должен проводиться до начала антибактериальной терапии, в противном случае результаты анализа будут недостоверными.
Брюшной тиф — это серьезное инфекционное заболевание, требующее тщательной диагностики. Люди часто обсуждают различные виды анализов, которые помогают выявить эту болезнь. Наиболее распространенным методом является бактериологический анализ, который позволяет обнаружить возбудителя в образцах крови или кала. Многие отмечают его высокую точность, но также упоминают, что результаты могут быть получены не сразу.
Среди других методов диагностики выделяют серологические тесты, которые определяют наличие антител к бактерии. Эти тесты часто используются в условиях ограниченного доступа к бактериологическим анализам, однако их чувствительность может быть ниже. Также обсуждают важность общего анализа крови, который помогает выявить воспалительные процессы в организме. В целом, пациенты и врачи подчеркивают, что комплексный подход к диагностике позволяет быстрее и точнее установить диагноз, что критично для успешного лечения.
https://youtube.com/watch?v=u7Scv44ZV3E
Серологические методы исследования
Серологические исследования – это специфические методы диагностики для выявления возбудителя. Их цель – обнаружение антител в сыворотке крови. При брюшном тифе антитела вырабатываются на 6-8 день заболевания.
РНГА (реакция непрямой гемагглютинации)
Это метод определения антигенов и антител с помощью эритроцитов, которые способны выпадать в осадок в присутствие антигенов. Предварительно антитела и антигены адсорбируются и сохраняются в таком виде на поверхности эритроцитов.
РНГА проводится в комплексной диагностике с другими тестами, при поиске источников заражения брюшным тифом в случае вспышки заболевания. Подготовка к исследованию:
- крови берут из локтевой вены;
- взятие материала должно производиться натощак;
- интервал между последним приемом пищи и сдачей крови не менее 8 часов.
РНГА брюшнотифозной диагностики обнаруживает Vi- и О-антитела. Для положительного результата минимальные диагностические титры должны составлять для Vi-антител – 1:80, для О-антител – 1:200.
https://youtube.com/watch?v=BIMAoKM-Gr0
РПГА (реакция пассивной гемагглютинации)
Это метод исследования, который выявляет в сыворотке крови специфические антитела к возбудителю заболевания.
РПГА-тест на антитела при брюшном тифе становится положительным к концу второй недели болезни. Для достоверности результатов анализ крови на брюшной тиф повторяют через 5 дней. Если инфекция носит острый характер, то титры растут.
Кровь для РПГА на брюшной тиф берут утром натощак из локтевой вены. Положительные диагностические значения титров для Vi-антител – 1:40, для О-антител – 1:200.
В диагностических целях могут быть использованы другие серологические методы:
- ИФМ – иммунофлюоресцентная микроскопия;
- ИФА – иммуноферментный анализ;
- реакция коагглютинации.
Клиническое исследование крови
При брюшном тифе в обязательном порядке делают общий анализ крови. Его основные показатели:
- лейкопения – лейкоциты в крови ниже нормы;
- анэозинофилия – отсутствие одного из вида лейкоцитов – эозинофилов;
- относительный лимфоцитоз – свидетельствует о снижении сопротивляемости организма;
- повышенное или умеренное СОЭ (скорость оседания эритроцитов);
- нейтрофильный лейкоцитоз – аномально высокое количество нейтрофилов – лейкоциты, которые вырабатываются иммунной системой в ответ на острый воспалительный процесс, при брюшном тифе – это бактериемия;
- тромбоцитопения – снижение количества тромбоцитов, отвечающих за свертываемость крови.
Общий анализ крови берут при поступлении больного в стационар, а также несколько раз во время лечения.
Бактериологическое исследование кала (копрокультура)
Этот метод диагностики используют не часто, так как тифозная палочка появляется в кале не ранее конца 2-й недели или начала 3-й недели болезни.
В основном такой способ используют для обследования людей на носительство
. Также бактериологический анализ кала на брюшной тиф делают для санкнижки работникам детских учреждений, общественного питания, водоснабжения.
Как берут материал:
- За 3-4 часа до взятия кала нужно принять 30 г магнезиальной соли, чтобы каловые массы сделать более мягкими.
- Материал для исследования нужно брать только из жидкой части.
- Если в кале обнаруживаются примеси крови, гноя, слизи, их обязательно собрать для анализа.
- Количество кала – 10-15 г, набирают деревянным или пластиковым стерильным шпателем и помещают в банку с широким горлом.
Лучше посев производить сразу же у постели больного. Если нет возможности немедленно доставить его в лабораторию, то кал вносят в специальный консервант.
Бактериологическое исследование мочи (уринокультура)
В пробах мочи тифозная палочка обнаруживается на 3-4 неделе заболевания. Правила сбора мочи для обследования:
- провести тщательный туалет наружных половых органов;
- у тяжелобольных мочу собирают с помощью катетера;
- необходимое количество мочи – 40-50 мл.
Мочу доставляют в лабораторию. Для посева используют осадок. Чтобы его получить, материал центрифугируют, а затем засевают на плотные питательные среды.
Бактериологическое исследование желчи (биликультура)
Чтобы получить порцию желчи для анализа, больному делают дуоденальное зондирование. Для лучшего отхождения желчи пациенту в двенадцатиперстную кишку через зонд вводят раствор магнезии объемом 40-50 мл. В пробирки собирают три порции – А, В, С, каждая объемом 5-10 мл.
Желчь засеивают во флаконы с питательным бульоном. Если желчь содержит хлопья или другие включения, то для исследования она не пригодна. Посевы помещают в термостаты с постоянной температурой 37°C и выращивают культуру в течение 20 часов.
Анализ на брюшной тиф с положительным результатом подтверждает наличие инфекции в организме. Отрицательные показатели говорят об отсутствии болезни или ее раннем периоде. Если результаты анализов ложноположительные, это может свидетельствовать о перекрестной реакции с другими инфекциями. Недостоверный ответ также может быть при приеме антибактериальных препаратов.
Вопрос-ответ
Каков основной метод диагностики брюшного тифа?
Исследование мочи, копрограмму, исследование стула, бактериологический посев биологического материала, крови, кала на питательные среды, чтобы культивировать возбудителя, выявить его и определить чувствительность к препаратам, серологические тесты, которые проводятся для оценки уровня антител к антигенам брюшного тифа.
Какой метод исследования проводится на 1 неделе при брюшном тифе?
Непрямая гемагглютинация. Тест позволяет выявить брюшной тиф в течение первой недели болезни. ИФА. Этот метод обладает высокой точностью и позволяет определять присутствие любых антител к антигенам бактерии.
Как определяют брюшной тиф?
Посев крови для выявления брюшнотифозных бактерий (начиная с первой недели заболевания) и посев кала (начиная со второй недели заболевания). Анализ крови на антитела к возбудителю брюшного тифа Salmonella typhi. УЗИ органов брюшной полости. Электрокардиографическое исследование (ЭКГ).
Что такое антитела к VI-антигену Salmonella typhi?
Антитела к Vi-антигену возбудителя брюшного тифа (S. Typhi) – это специфические белки-иммуноглобулины, вырабатываемые иммунной системой в ответ на инфицирование возбудителем брюшного тифа и участвующие в реакциях иммунной защиты организма. Анти-Vi-антитела, возбудитель брюшного тифа.
Советы
СОВЕТ №1
Перед сдачей анализов обязательно проконсультируйтесь с врачом. Он поможет определить, какие именно тесты необходимы для диагностики брюшного тифа в вашем случае, и объяснит, как правильно подготовиться к ним.
СОВЕТ №2
Обратите внимание на сроки проведения анализов. Некоторые тесты, такие как посев крови, требуют определенного времени для получения результатов, поэтому планируйте свои визиты к врачу заранее.
СОВЕТ №3
Не забывайте о важности повторных анализов. В некоторых случаях для подтверждения диагноза может потребоваться сдать анализы повторно, особенно если первоначальные результаты были неясными.
СОВЕТ №4
Следите за своим состоянием и записывайте все симптомы. Это поможет врачу лучше понять вашу ситуацию и выбрать наиболее подходящие анализы для диагностики брюшного тифа.